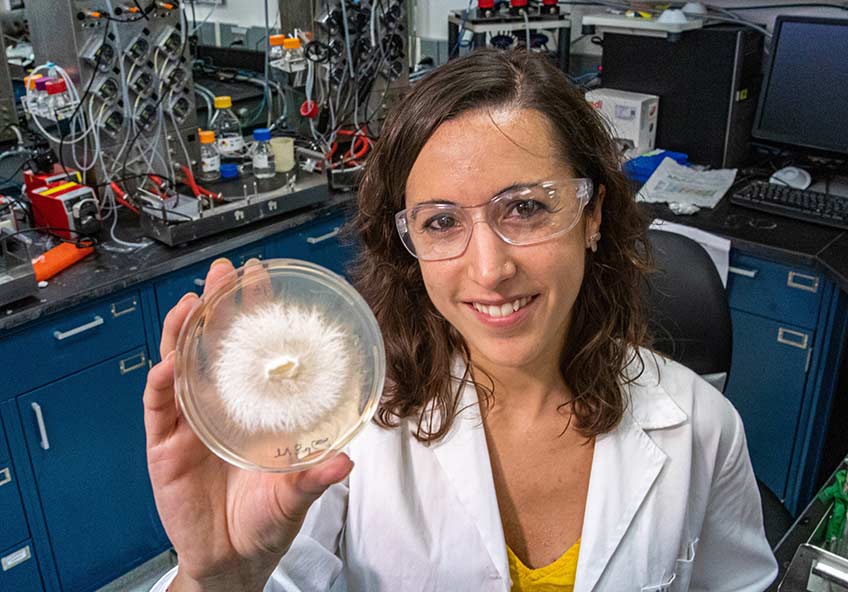

Σύνταξη – Επιμέλεια: Στέλιος Βασιλούδης
Οι κοινοί μικροοργανισμοί υπερέχουν στην απορρόφηση του άνθρακα από την ατμόσφαιρα – σύντομα θα κάνουν την εμφάνισή τους στα πιάτα και στις ντουλάπες μας. Οι μύκητες, συχνά (και επίσης άδικα) θεωρούνται κατώτεροι από το φυτικό και ζωικό βασίλειο, όμως αυτοί οι μικροοργανισμοί έχουν τη δυνατότητα να βοηθήσουν στη διάσωση του κόσμου από τις καταστροφικές συνέπειες της κλιματικής αλλαγής.
Ακριβώς κάτω από τα πόδια μας, υπάρχει ένα τεράστιο σύμπαν μυκήτων που έχει κάνει εφικτή τη ζωή στο πλανήτη Γη. Αυτοί οι κύριοι ανακυκλωτές απελευθερώνουν θρεπτικά συστατικά που συντηρούν τη ζωή των φυτών και καθηλώνουν άνθρακα στο έδαφος – δεσμεύοντας τον από τον αέρα. Η επιφάνεια του εδάφους σε βάθος ενός μέτρου, περιέχει τρεις φορές περισσότερο άνθρακα από ολόκληρη την ατμόσφαιρα, καθιστώντας την μια σημαντική δεξαμενή άνθρακα, παράλληλα με τα δάση και τους ωκεανούς.
Τώρα, μια νέα γενιά επιστημόνων, αγροτών και εταιρειών βιοτεχνολογίας, διερευνούν τη χρήση μυκήτων για να βελτιώσουν την ικανότητα των φυτών να απορροφούν διοξείδιο του άνθρακα από τον αέρα και να το αποθηκεύουν στο έδαφος μακροπρόθεσμα. Δεν αρκεί απλώς να περιορίσουμε τις εκπομπές διοξειδίου του άνθρακα που απελευθερώνουμε στην ατμόσφαιρα – για να αντιμετωπίσουμε την κλιματική αλλαγή, πρέπει να μειώσουμε την ποσότητα που υπάρχει ήδη.
Οι ερευνητές διαλέγουν τους καλύτερους μύκητες, από ένα εκτιμώμενο τρισεκατομμύριο διαφορετικά μικροβιακά είδη, για την αποθήκευση τεράστιων επιπέδων άνθρακα στο έδαφος. Η Εταιρεία για την Προστασία των Υπόγειων Δικτύων (SPUN), μια μη κερδοσκοπική ομάδα επιστημόνων, έχει χαρτογραφήσει τους τεράστιους υπόγειους ιστούς μυκήτων του κόσμου. Οι ερευνητές συλλέγουν 10.000 δείγματα από όλο τον κόσμο και χρησιμοποιούν μηχανική μάθηση για να ανακαλύψουν περιοχές βιοποικιλότητας που θα μπορούσαν να προστατεύσουν καλύτερα τα φυσικά οικοσυστήματα και να αποθηκεύσουν άνθρακα, καθώς και να εντοπίσουν περιοχές που κινδυνεύουν.
Στην Loam Bio, έχουν ήδη καταρτίσει μια ποικιλόμορφη βιβλιοθήκη χιλιάδων μυκήτων που έχουν απομονωθεί από όλη την Αυστραλία και τη Βόρεια Αμερική, πολλοί από τους οποίους είναι σχετικά νέοι στην επιστήμη. Η ομάδα έχει χρησιμοποιήσει γενετική αλληλουχία και τα πιο πρόσφατα εργαλεία βιοπληροφορικής για να αποκτήσει καλύτερη κατανόηση της εσωτερικής λειτουργίας αυτών των οργανισμών, το πώς αλληλοεπιδρούν με τα φυτά και πως επηρεάζουν την αποθήκευση άνθρακα στο έδαφος. Μετά από χρόνια έρευνας στο εργαστήριο, το θερμοκήπιο και το χωράφι, αναπτύχθηκαν τα πρώτα προϊόντα: μικροβιακές επικαλύψεις σπόρων που ενισχύουν τη δέσμευση άνθρακα στις γεωργικές καλλιέργειες.
Το 2023, οι αγρότες θα αρχίσουν να χρησιμοποιούν τέτοια εμπορικά προϊόντα με βάση τους μύκητες για την καταπολέμηση της κλιματικής αλλαγής. Οι αγρότες στην Αυστραλία εφαρμόζουν από τώρα ένα τέτοιο προϊόν στους σπόρους τους πριν φυτέψουν καλλιέργειες. Αποτελείται από ωφέλιμους μύκητες που αναπτύσσονται στις ρίζες των φυτών αφού βλαστήσουν. Το φυτό αντλεί διοξείδιο του άνθρακα από τον αέρα και παράγει απλά σάκχαρα μέσω της φωτοσύνθεσης.
Οι μύκητες τα μετατρέπουν σε σύνθετες και μακροχρόνιες ενώσεις άνθρακα και παίζουν καθοριστικό ρόλο στη μετατροπή των ενώσεων άνθρακα που διασπώνται εύκολα στο έδαφος σε μακροπρόθεσμα σταθερές μορφές. Μερικά από αυτά συνδέονται με μέταλλα στο έδαφος και παραμένουν εκεί για εκατοντάδες ή, σε ορισμένες περιπτώσεις, χιλιάδες χρόνια. Εάν, για παράδειγμα, αυτή η τεχνολογία εφαρμοζόταν σε όλες τις καλλιέργειες σόγιας σε ολόκληρη την Αμερική, θα αντιστάθμιζε τις ισοδύναμες εκπομπές ολόκληρης της αεροπορικής βιομηχανίας των ΗΠΑ, σε ετήσια βάση.
Η Loam Bio ήδη συνεργάζεται με εταιρείες όπως η αυστραλιανή εταιρεία παραγωγής σιτηρών GrainCorp για την πιλοτική εφαρμογή αυτής της τεχνολογίας. Το 2023, θα κυκλοφορήσει το πρώτο μικροβιακό προϊόν για την αύξηση του άνθρακα του εδάφους – σε κλίμακα – σε συνεργασία με τους Αυστραλούς καλλιεργητές σιτηρών πριν από την ανάπτυξη του στις ΗΠΑ.

Οι μύκητες ανοίγουν νέους δρόμους παντού. Ο μύκητας μυκήλιο έχει κυκλοφορήσει στην αγορά ως vegan υποκατάστατο του δέρματος. Οι μύκητες αναπτύσσονται σε ελεγχόμενο περιβάλλον και στη συνέχεια υφίστανται επεξεργασία και μετατρέπονται σε φύλλα από ένα υλικό που μοιάζει στην υφή, με δέρμα. Εταιρείες όπως η Lululemon, η Stella McCartney και η Adidas έχουν ήδη αποκαλύψει τα πρώτα προϊόντα «mylo» – έχουν χρησιμοποιήσει επίσης το μυκήλιο ως συνδετικό παράγοντα για τη συγκράτηση των σωματιδίων του ξύλου για επένδυση, καθώς και για ένα, ανθεκτικό στη φωτιά, ελαφρύ υλικό συσκευασίας. Η Startup MyForest Foods ανακοίνωσε το άνοιγμα μιας κάθετης φάρμας κοντά στο Albany της Νέας Υόρκης, όπου σχεδιάζει να καλλιεργήσει περίπου 3 εκατομμύρια κιλά μυκηλίου ετησίως, αρκετά για την παραγωγή ενός εκατομμυρίου κιλών μπέικον (απομίμησης).
Εάν γίνει εφικτό να εκμεταλλευτούμε την αναξιοποίητη δύναμη των μυκήτων και να την εφαρμόσουμε σε γεωργικές εκτάσεις – 1,8 δισεκατομμύρια εκτάρια παγκοσμίως – θα μπορούσαμε να πετύχουμε το μεγαλύτερο γεγονός της μείωσης του άνθρακα στην ιστορία. Ένας ετήσιος ρυθμός αύξησης μόνο 0,4% των παγκόσμιων αποθεμάτων οργανικού άνθρακα του εδάφους θα μπορούσε να αντισταθμίσει την τρέχουσα αύξηση του ατμοσφαιρικού διοξειδίου του άνθρακα. Είναι καιρός οι μύκητες να τραβήξουν την προσοχή που τους αξίζει.
Πηγή: Wired

